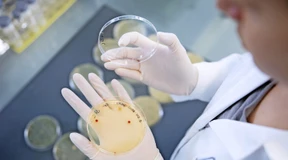
Wie sollen wir im Genom heilen?

Unterbrechung in Patentklage
Die Patentklage von Moderna, die Pfizer und Biontech vorwirft, ihre Covid-19-Impfstofftechnologie kopiert zu haben, ist vorläufig auf Eis gelegt worden.
Die Patentklage von Moderna, die Pfizer und Biontech vorwirft, ihre Covid-19-Impfstofftechnologie kopiert zu haben, ist vorläufig auf Eis gelegt worden.
Gefährliche Krankheiten im Erbgut heilen. Das geht mit der „Genschere“, aber vielleicht bald schon eleganter mit dem Genom-Skalpel. Kann es die Genrevolution revolutionieren?

Der Mainzer mRNA-Pionier schlägt sich im abflauenden Corona-Geschäft wacker. Der Fokus liegt aber klar auf dem Zukunftsgeschäft mit neuen Therapien gegen Krebs. Hier hat sich das Unternehmen bis 2030 viel vorgenommen.

Der Kanzler wünscht sich deutsche Innovationen? Hier ist eine: Ein deutscher Immunologe spricht im Podcast über seine Breitbandwaffen gegen HIV. Ein Ende der größten Gesundheitskrise der Neuzeit nach 35 Millionen Toten?

Inzwischen werden einige mRNA-Impfungen gegen Krebs in Patientenstudien getestet. Die Hoffnungen sind groß, aber wie berechtigt sind sie?

Die Pharmaindustrie setzt im Jahr 1,5 Billionen Dollar um. Innovation treibt das Geschäft, deshalb stecken die Unternehmen viel Geld in ihre Forschung. 2023 sollen es 262 Milliarden Dollar sein. Für Deutschland geht es derzeit darum, den Anschluss an die Weltspitze nicht zu verlieren. Die Branche steht auch im Ausland vor Herausforderungen.
Jean-Marc Huët soll neuer Verwaltungsratspräsident des Pharma-Auftragsherstellers Lonza werden. Damit hofft das Unternehmen auf ruhigere Zeiten.

Wegen angeblicher Impfschäden verklagen in ganz Deutschland Geimpfte die Pharmaunternehmen. In Frankfurt hat nun das erste Verfahren Hessens gegen Biontech begonnen.

Die vor den Nationalsozialisten nach Schweden geflohene Malerin Lotte Laserstein wird postum von ihrem Exilland mit einer großen Retrospektive geehrt.

Die neue Einundneunzig Galerie in Frankfurt zeigt junge Kunst aus der Ukraine. Den Auftakt macht eine Schau des Kiewer Künstlers Nikita Kadan. Sein Werk über ein Massaker an Juden in den Vierzigerjahren bekommt nun eine neue Aktualität.
Der US-Pharmakonzern Moderna hofft darauf, in zwei Jahren einen Impfstoff gegen schwarzen Hautkrebs auf den Markt zu bringen.

Als Erzählerin der kurzen Form ist die amerikanische Klassikerin Willa Cather, die vor 150 Jahren geboren wurde, in Deutschland kaum bekannt. Jetzt ist eine schöne Auswahl, übersetzt von Agnes Krup, in der Anderen Bibliothek erschienen.

„Der Herr der Ringe“ wird von der politischen Linken ebenso gern gelesen wie von der Rechten. Eine Ausstellung in Rom widmet sich nun den Werken Tolkiens - begeistert gefördert von der amtierenden Ministerpräsidentin Meloni.

J. R. R. Tolkien ist die intellektuelle Säule für Italiens Rechte. Jetzt hat Ministerpräsidentin Giorgia Meloni in Rom eine Ausstellung über ihren Lieblingsautor miteröffnet.

Das Landgericht Düsseldorf hat Schmerzensgeldklagen gegen Vakzinhersteller wegen mutmaßlicher Schäden durch Corona-Impfungen zurückgewiesen. Der Klägeranwalt kündigte Berufung an.

Statt der bisher angenommenen 5 Milliarden Euro dürften sich die Biontech-Erlöse im laufenden Geschäftsjahr nur noch auf 4 Milliarden Euro belaufen. Doch man trotze dem Branchentrend, sind die Mainzer überzeugt.

Auch Biontech spürt die geringere Nachfrage nach Corona-Impfstoffen. Das Mainzer Unternehmen rechnet für 2023 nur noch mit einem Umsatz von rund vier Milliarden Euro. In die roten Zahlen rutscht Biontech aber nicht.

Glücklich die Kunst, unselig das transhistorische Kontextualisieren: Belgien zeigt in Leuven die größte Schau des spätgotischen Malers Dieric Bouts seit Jahrzehnten.
Der US-Pharmakonzern Pfizer senkt wegen der geringeren Nachfrage nach seinem Corona-Vakzin Comirnaty und seinem Corona-Mittel Paxlovid die Umsatzprognose für das Gesamtjahr.

Weil Covid-Mittel wie Paxlovid inzwischen schlechter laufen, erwartet das amerikanische Pharmaunternehmen Pfizer für dieses Jahr weniger Umsatz und Gewinn. Zudem muss es eine Milliardenabschreibung vornehmen.

Drei Nobelpreise, drei Meilensteine: Die Hintergründige zu mRNA-Impfstoffen, unvorstellbar kurzen Lichtpulsen und bunten Quantenpunkten. Und dann waren da noch die neuen Befunde über die Großtaten der Regenwürmer.

Curevac war der große Verlierer in der Corona-Pandemie. Ein Gespräch mit Vorstandschef Alexander Zehnder über die Zukunft des Impfstoffherstellers – und warum der Medizinnobelpreis auch dem Unternehmen nützt.

Beharrlichkeit, Glück und Durchhaltevermögen: Der Weg der beiden frisch gekürten Laureaten von der fixen Idee zum Medizin-Nobelpreis war gepflastert mit Stolpersteinen. Ein Lehrstück über modernen Forschergeist.

Durch den Welterfolg von Biontech ist Mainz zu einer wohlhabenden Kommune geworden. Allerdings kann die rheinland-pfälzische Landeshauptstadt es sich nicht leisten, sich auf dem neuen Polster auszuruhen.

Ein Machtwort der Nobelorganisation: Warum der Medizin-Nobelpreis für die unbeirrbaren und immer wieder angefeindeten Entwickler von mRNA-Impfstoffen mehr als verdient ist.

Die in Ungarn geborene Katalin Karikó und der Amerikaner Drew Weissman erhalten den Medizin-Nobelpreis für ihre Grundlagenforschung zu mRNA-Impfstoffen gegen Covid-19. Das gab das Karolinska-Institut in Stockholm bekannt.
Angepasste Impfstoffe sollen vor schweren Krankheitsverläufen schützen. Die Impfkommission lässt ihre Empfehlungen unverändert.

Das Gesundheitssystem wird wegen Corona und anderer Erreger im Herbst stark belastet, sagen Fachleute. Nun steht erst einmal ein neuer Impfstoff zur Verfügung.

Eine einzige Impfung gegen Corona und gegen Grippe? Was bequem klingt, dürfte noch etwas auf sich warten lassen. Der Hersteller Moderna verweist auf das übernächste Jahr.

Ein hochgradig mutierter Omikron-Erreger gibt Rätsel auf, und das nächste Impfkapitel kündigt sich schon an. Wie geht es weiter mit Covid?

Bei Kleinkindern kann das Respiratorische Synzytial-Virus schwere Atemwegserkrankungen auslösen. Die EU-Kommission hat nun einen Impfstoff zugelassen, der werdenden Müttern verabreicht wird – zur passiven Immunisierung von Babys.

Mutmaßliche Corona-Impfgeschädigte verklagen den Staat auf Schadenersatz und Schmerzensgeld. Es geht um angebliche ärztliche Aufklärungsfehler.

Vor 50 Jahren nahmen zwei Räuber bei einem Banküberfall in Schweden Geiseln, darunter eine junge Frau. Opfer und Täter kamen sich näher. Seither ist vom Stockholm-Syndrom die Rede. Doch ist der psychologische Effekt echt? Oder nur ein Mythos der Medien?

Der Swiss Market Index hinkt dem Dax bisher hinterher. Warum es im zweiten Halbjahr umgekehrt sein könnte.

Es ist ein Streit zwischen zwei Pionieren, die sich unterschiedlich entwickelten. Vor Gericht verlangt Curevac nun umfassend Auskunft von Biontech über die Nutzung der wegweisenden mRNA-Technologie.

Das Mainzer Biotechunternehmen erweitert seine Führungsebene um einen Chefjustiziar.